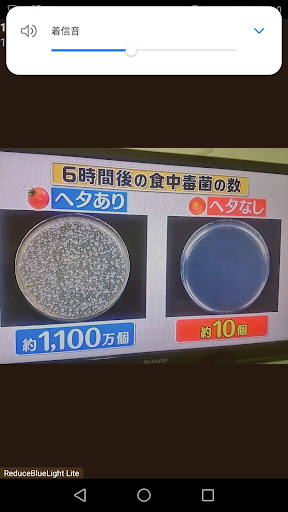

昇吾楼 things to do, attractions, restaurants, events info and trip planning
Basic Info
昇吾楼
35-5-9 Mikunicho Yamagishi, Sakai, Fukui 913-0032, Japan
3.4(8)$$$$
Save
spot
spot
Ratings & Description
Info
attractions: Roadside Station Mikuni, Techno Port Fukui Park, restaurants: はんすう 道の駅みくに店 〜浅藤牧場〜(道の駅 みくに ふれあいパーク三里浜), local businesses: Fureai Park Sanrihama, Local Products Shop
 Learn more insights from Wanderboat AI.
Learn more insights from Wanderboat AI.Phone
+81 776-81-3100
Website
big-advance.site
Plan your stay

Pet-friendly Hotels in Sakai
Find a cozy hotel nearby and make it a full experience.

Affordable Hotels in Sakai
Find a cozy hotel nearby and make it a full experience.

The Coolest Hotels You Haven't Heard Of (Yet)
Find a cozy hotel nearby and make it a full experience.

Trending Stays Worth the Hype in Sakai
Find a cozy hotel nearby and make it a full experience.
Reviews
Nearby attractions of 昇吾楼
Roadside Station Mikuni
Techno Port Fukui Park

Roadside Station Mikuni
3.6
(1.5K)
Closed
Click for details
Techno Port Fukui Park
3.8
(106)
Closed
Click for details
Nearby restaurants of 昇吾楼
はんすう 道の駅みくに店 〜浅藤牧場〜(道の駅 みくに ふれあいパーク三里浜)

はんすう 道の駅みくに店 〜浅藤牧場〜(道の駅 みくに ふれあいパーク三里浜)
3.7
(33)
Closed
Click for details
Nearby local services of 昇吾楼
Fureai Park Sanrihama
Local Products Shop
Fureai Park Sanrihama
3.6
(651)
Click for details

Local Products Shop
4.0
(22)
Click for details